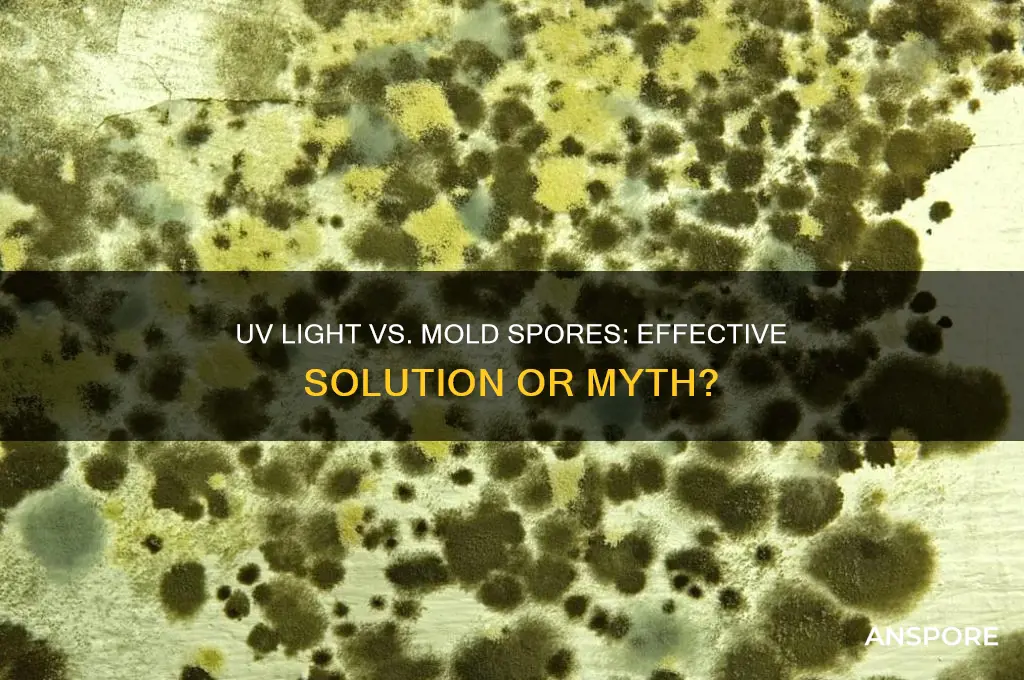
can you use uv light to kill mold spores

Ultraviolet (UV) light has gained attention as a potential method for killing mold spores, which are notorious for their resilience and ability to thrive in damp, dark environments. Mold spores can pose health risks and damage surfaces, making their eradication essential in homes, healthcare facilities, and industrial settings. UV light, particularly UV-C radiation, is known for its germicidal properties, effectively disrupting the DNA of microorganisms, including mold spores, rendering them unable to reproduce. While UV light shows promise in reducing mold populations, its effectiveness depends on factors such as exposure duration, intensity, and the accessibility of the spores to the light source. However, UV light alone may not eliminate deeply embedded mold or address the underlying moisture issues that foster mold growth, necessitating a comprehensive approach to mold remediation.
| Characteristics | Values |
|---|---|
| Effectiveness | UV-C light (100-280 nm) can kill mold spores by damaging their DNA, but effectiveness depends on intensity, duration, and proximity to the light source. |
| Optimal Wavelength | 254 nm (UV-C range) is most effective for mold spore inactivation. |
| Limitations | UV light cannot penetrate surfaces, so it only works on exposed mold spores. It is ineffective for hidden or embedded mold. |
| Safety Concerns | Prolonged exposure to UV-C light is harmful to humans and pets, causing skin and eye damage. Requires proper shielding and controlled use. |
| Applications | Commonly used in HVAC systems, air purifiers, and surface disinfection devices, but not as a standalone solution for mold remediation. |
| Complementary Methods | Often used in conjunction with physical removal, dehumidification, and other mold control strategies for comprehensive treatment. |
| Energy Efficiency | UV-C lamps consume relatively low energy but require regular replacement due to decreasing efficacy over time. |
| Cost | Initial setup and maintenance costs can be moderate to high, depending on the system size and complexity. |
| Environmental Impact | UV-C light does not produce chemical byproducts, making it an environmentally friendly option when used correctly. |
| Regulatory Compliance | Must adhere to safety standards (e.g., OSHA, EPA) for installation and operation in residential or commercial settings. |
Explore related products
$50.72 $53.39
What You'll Learn

UV Light Effectiveness on Mold Spores
UV light, particularly in the UVC range (200-280 nanometers), has been shown to effectively inactivate mold spores by damaging their DNA, rendering them unable to reproduce. This method is widely used in industrial and commercial settings, such as HVAC systems and water treatment plants, where mold contamination is a persistent issue. For instance, a study published in the *Journal of Applied Microbiology* found that exposure to UVC light at a wavelength of 254 nm for 15-30 minutes reduced mold spore viability by over 99%. However, the effectiveness of UV light depends on factors like exposure duration, intensity, and the surface material where mold is present.
To implement UV light for mold control at home, consider using UVC lamps designed for air purification or surface disinfection. For air treatment, a UVC lamp with an output of at least 30 watts can be installed in HVAC systems to neutralize airborne spores. For surface mold, handheld UVC devices emitting 1-5 mW/cm² should be held 6-12 inches from the affected area for 10-20 minutes. It’s crucial to ensure the area is free of shadows, as UV light must directly contact spores to be effective. Always follow manufacturer guidelines and avoid skin or eye exposure to UVC radiation.
While UV light is potent against mold spores, it has limitations. It cannot penetrate porous materials like drywall or wood, meaning surface-level mold may be treated, but hidden spores remain unaffected. Additionally, UVC light degrades over time, requiring regular replacement of bulbs to maintain efficacy. For example, a typical UVC bulb loses 20-30% of its output after 1,000 hours of use. Combining UV treatment with physical removal of mold and moisture control is essential for comprehensive mold management.
Comparatively, UV light offers advantages over chemical treatments, such as bleach or fungicides, which can be toxic and leave residues. UV treatment is chemical-free, non-invasive, and leaves no harmful byproducts. However, it is less effective in humid environments, as moisture can shield spores from UV radiation. For optimal results, maintain relative humidity below 50% and address water leaks or condensation issues before applying UV treatment. This dual approach ensures both immediate spore inactivation and long-term mold prevention.
In practical terms, UV light is a valuable tool for mold control but not a standalone solution. For small-scale applications, such as treating mold on bathroom tiles, a handheld UVC device can be effective when used correctly. For larger areas or systemic mold issues, professional-grade UV systems are recommended. Always pair UV treatment with preventive measures like dehumidification and ventilation to create an environment hostile to mold growth. By understanding UV light’s strengths and limitations, homeowners and professionals can harness its power effectively in the fight against mold.
Does Staphylococcus Aureus Form Spores? Unraveling the Myth
You may want to see also

Optimal UV Wavelength for Mold Eradication
UV light's effectiveness against mold spores hinges on wavelength precision. While the broader UV spectrum (100–400 nm) holds antimicrobial potential, mold eradication requires targeting the 250–280 nm range, specifically peaking at 254 nm. This narrow band, known as UV-C, disrupts nucleic acids in mold spores, rendering them incapable of replication. Shorter wavelengths (below 250 nm) risk generating ozone, a respiratory irritant, while longer wavelengths (above 280 nm) lack sufficient energy to penetrate spore cell walls effectively.
Selecting the optimal UV wavelength is only half the battle. Dosage, measured in millijoules per square centimeter (mJ/cm²), determines eradication success. For mold spores on surfaces, a minimum dosage of 10–20 mJ/cm² at 254 nm is recommended. However, factors like spore type, surface material, and environmental humidity influence required exposure time. For instance, porous materials like wood may necessitate higher dosages due to spore penetration.
Practical application demands caution. UV-C light is harmful to human skin and eyes, necessitating unmanned operation during treatment. Enclosed UV-C systems, such as those integrated into HVAC units or standalone air purifiers, offer controlled exposure without human risk. For surface treatment, handheld UV-C devices with automated shut-off mechanisms ensure safe usage. Always follow manufacturer guidelines for distance, exposure time, and protective measures.
Comparing UV-C to chemical treatments highlights its advantages and limitations. While UV-C avoids chemical residue and resistance development, its effectiveness is limited to line-of-sight exposure, making it unsuitable for shadowed areas. Chemical treatments, though more versatile, pose health and environmental risks. Combining both methods—using UV-C for accessible surfaces and chemicals for hidden areas—maximizes mold eradication efficiency.
In conclusion, the 254 nm wavelength stands as the gold standard for mold spore eradication, but success relies on precise dosage, controlled application, and awareness of limitations. By understanding these parameters, users can harness UV-C technology effectively, ensuring a mold-free environment without compromising safety.
Destroying Spores in Food: Simple Methods or Complex Challenge?
You may want to see also

UV Light vs. Mold on Surfaces
UV-C light, a subset of ultraviolet light with wavelengths between 200 and 280 nanometers, has been shown to effectively inactivate mold spores by damaging their DNA, rendering them unable to reproduce. This method is particularly appealing for surface treatment because it’s chemical-free and leaves no residue. However, its effectiveness depends on direct exposure: UV-C light cannot penetrate shadows, textures, or layers of debris, meaning surfaces must be thoroughly cleaned before application. For instance, a study in the *Journal of Applied Microbiology* found that 10 minutes of UV-C exposure at 1.7 mW/cm² reduced mold spore viability by 99% on flat, unobstructed surfaces.
To use UV-C light for mold remediation, follow these steps: first, remove visible mold and clean the surface with a detergent or mold-specific cleaner to eliminate organic matter that can shield spores. Next, position a UV-C lamp 6 to 12 inches from the surface, ensuring even coverage. Exposure times vary by device, but most industrial-grade lamps require 15 to 30 minutes per area. Always wear protective gear, including UV-blocking goggles and gloves, as UV-C light is harmful to skin and eyes. Portable UV-C wands or room-sized units are available for residential use, but consistency in application is key—missed spots can allow mold to regrow.
While UV-C light is effective on surfaces, it has limitations. It cannot treat porous materials like drywall or wood, where mold roots deep within the material. Additionally, prolonged exposure to UV-C can degrade certain plastics and fabrics, so test surfaces for compatibility before full-scale treatment. For example, a 2020 study in *Environmental Science & Technology* noted that repeated UV-C treatments caused discoloration in painted surfaces after 10 cycles. This makes it unsuitable for frequent use in aesthetic-sensitive areas.
Comparatively, traditional methods like bleach or hydrogen peroxide offer broader penetration but leave chemical residues and require ventilation. UV-C light, on the other hand, is ideal for high-touch areas like countertops, tiles, and glass, where chemical use is undesirable. However, it’s not a standalone solution—combine it with HEPA filtration and humidity control for comprehensive mold management. For instance, in healthcare settings, UV-C is often used as a supplementary measure after physical cleaning to ensure sterile surfaces.
In practice, UV-C light is best suited for smooth, non-porous surfaces in controlled environments. Homeowners should pair it with preventive measures like dehumidifiers and regular inspections, especially in moisture-prone areas like bathrooms and basements. While not a cure-all, when used correctly, UV-C light can significantly reduce mold spore counts, improving indoor air quality and surface hygiene. Always consult manufacturer guidelines for your specific device to ensure safe and effective use.
Breloom's Spore Ability: Mirror Herb's Role in Learning the Move
You may want to see also
Explore related products

Safety Concerns of UV Mold Treatment
UV-C light, the type of ultraviolet radiation effective against mold spores, is a double-edged sword. While its germicidal properties are well-documented, its potential harm to humans and animals cannot be overlooked. Direct exposure to UV-C radiation can cause skin irritation, resembling a severe sunburn, and eye damage, including photokeratitis, a painful inflammation of the cornea. Prolonged or repeated exposure increases the risk of skin cancer, particularly for individuals with fair skin or a history of skin cancer. Therefore, it is crucial to ensure that UV-C mold treatment devices are used in unoccupied spaces and that all living beings are evacuated during operation.
The effectiveness of UV-C light in killing mold spores depends on several factors, including the intensity of the light, the duration of exposure, and the distance between the light source and the mold. Most UV-C lamps used for mold treatment emit radiation at a wavelength of 254 nanometers, which is optimal for destroying the DNA of mold spores. However, to achieve complete eradication, the spores must be exposed to a minimum dose of 10,000 microwatt-seconds per square centimeter. This requires careful positioning of the UV-C lamp and sufficient treatment time, typically ranging from 30 minutes to several hours, depending on the severity of the mold infestation.
One of the most significant safety concerns with UV mold treatment is the potential for indirect exposure. UV-C radiation can reflect off surfaces, such as walls, floors, and furniture, increasing the risk of accidental exposure. Additionally, some materials, like plastics and textiles, can degrade when exposed to UV-C light, releasing harmful chemicals or particles into the air. To mitigate these risks, it is essential to cover or remove sensitive items from the treatment area and ensure proper ventilation after the treatment is complete. Using UV-C devices with built-in safety features, such as automatic shut-off mechanisms and motion sensors, can further reduce the likelihood of accidental exposure.
Another critical aspect of UV mold treatment safety is the proper handling and maintenance of UV-C lamps. These lamps contain mercury, a toxic substance that can be released if the lamp breaks. To minimize this risk, always handle UV-C lamps with care, avoiding drops or impacts. If a lamp does break, follow EPA guidelines for cleaning up mercury spills, including evacuating the area, shutting off heating or air conditioning systems, and using stiff paper or cardboard to pick up visible mercury droplets. Never use a vacuum cleaner, as this can spread mercury vapor into the air. Regularly inspect UV-C lamps for signs of wear or damage, and replace them according to the manufacturer’s recommendations, typically every 9,000 to 14,000 hours of use.
While UV-C light is a powerful tool for mold remediation, it is not a standalone solution. Mold thrives in damp, humid environments, so addressing the underlying moisture problem is essential to prevent recurrence. Combine UV mold treatment with other strategies, such as improving ventilation, fixing leaks, and using dehumidifiers to maintain indoor humidity levels below 50%. For individuals with mold allergies or respiratory conditions, consult a healthcare professional before attempting UV mold treatment, as even dead mold spores can trigger symptoms. By adopting a comprehensive approach and prioritizing safety, UV-C light can be an effective component of a mold remediation plan.
Overriding Spore's Complexity Meter: Possibilities and Limitations Explained
You may want to see also

Duration of UV Exposure for Mold Removal
UV light's effectiveness against mold spores hinges on exposure duration, a critical factor often overlooked in DIY remediation attempts. While UV-C light, particularly in the 254 nm wavelength range, is proven to disrupt mold DNA and prevent reproduction, the required exposure time varies significantly. Factors like mold species, spore concentration, and surface material influence the necessary duration. For instance, *Aspergillus niger*, a common household mold, may require up to 15 minutes of direct exposure, whereas *Cladosporium*, another prevalent type, might succumb in as little as 5 minutes. However, these times assume optimal conditions—unobstructed light paths and clean surfaces—rarely found in real-world scenarios.
To achieve effective mold spore eradication, follow a structured approach. Begin by cleaning the surface to remove dirt and debris, ensuring UV light penetration. Position the UV-C lamp 6 to 12 inches from the target area, maintaining this distance throughout the process. For moderate mold infestations, start with 15-minute exposure cycles, monitoring progress after each session. Heavily contaminated areas may demand 30 minutes or more, divided into multiple sessions to prevent overheating the UV source. Always prioritize safety: wear protective eyewear and avoid skin exposure, as UV-C radiation can cause burns and eye damage.
A comparative analysis reveals that UV light’s efficacy diminishes with distance and obstacles. For example, a study in *Applied and Environmental Microbiology* found that UV-C’s mold-killing power drops by 50% when the light source is moved from 6 to 12 inches away. Similarly, porous materials like wood or fabric may require longer exposure times due to light absorption. In contrast, smooth surfaces like glass or tile allow for more efficient spore neutralization. This underscores the importance of tailoring exposure duration to the specific context rather than applying a one-size-fits-all approach.
Persuasively, UV light offers a chemical-free alternative to mold removal, but its success depends on precision. Over-reliance on short exposure times can lead to incomplete eradication, allowing spores to regrow. Conversely, excessive exposure may damage surrounding materials or increase safety risks. For optimal results, combine UV treatment with preventive measures like humidity control and ventilation. While UV-C lamps are accessible tools, their use demands respect for both their potential and limitations. When applied correctly, they can be a powerful ally in maintaining mold-free environments.
Are All Spore-Forming Bacteria Gram-Positive? Unraveling the Myth
You may want to see also
Frequently asked questions
Yes, UV light, specifically UV-C light, can effectively kill mold spores by damaging their DNA and preventing them from reproducing.
UV-C light, with a wavelength of 200-280 nanometers, is the most effective type for killing mold spores due to its germicidal properties.
The time required varies, but typically 10-60 minutes of direct exposure to UV-C light is sufficient to kill most mold spores, depending on the intensity of the light and proximity to the source.
UV light can be safe for mold removal if used correctly, but it should not be used in occupied spaces as direct exposure to UV-C light can harm skin and eyes. Always follow safety guidelines and consider professional assistance.






























